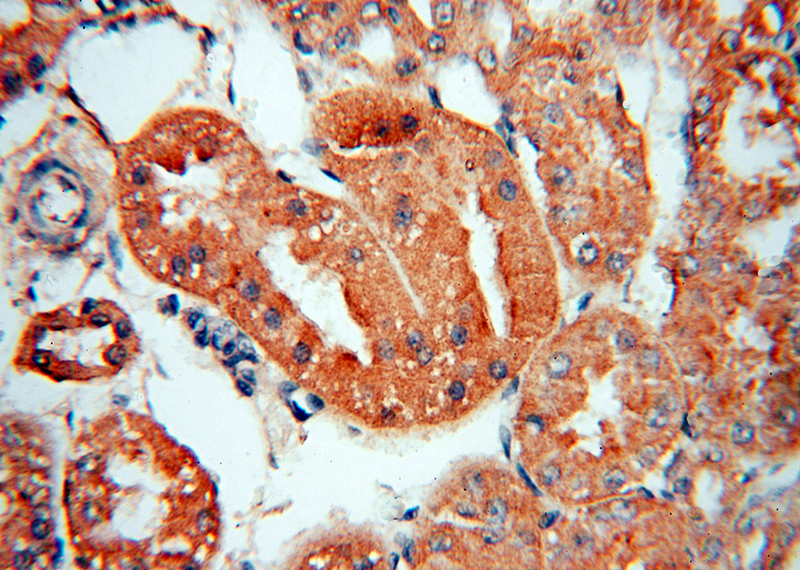
Immunohistochemical of paraffin-embedded human kidney using Catalog No:116346(TRAPPC9,NIBP antibody) at dilution of 1:50 (under 40x lens)

-
Product Name
TRAPPC9 antibody
- Documents
-
Description
TRAPPC9 Rabbit Polyclonal antibody. Positive IHC detected in human kidney tissue, human heart tissue. Positive IF detected in HEK-293 cells. Positive WB detected in mouse brain tissue, human brain tissue, human skeletal muscle tissue, mouse skeletal muscle tissue. Positive IP detected in mouse brain tissue. Observed molecular weight by Western-blot: 128-140 kDa
-
Tested applications
ELISA, WB, IHC, IF, IP
-
Species reactivity
Human,Mouse,Rat,Zebrafish; other species not tested.
-
Alternative names
IBP antibody; IKBKBBP antibody; KIAA1882 antibody; NIBP antibody; NIK and IKBKB binding protein antibody; TRAPPC9 antibody; TRS120 antibody; Tularik gene 1 protein antibody
-
Isotype
Rabbit IgG
-
Preparation
This antibody was obtained by immunization of TRAPPC9 recombinant protein (Accession Number: BC006206). Purification method: Antigen affinity purified.
-
Clonality
Polyclonal
-
Formulation
PBS with 0.02% sodium azide and 50% glycerol pH 7.3.
-
Storage instructions
Store at -20℃. DO NOT ALIQUOT
-
Applications
Recommended Dilution:
WB: 1:200-1:2000
IP: 1:200-1:2000
IHC: 1:20-1:200
IF: 1:20-1:200
-
Validations

mouse brain tissue were subjected to SDS PAGE followed by western blot with Catalog No:116346(TRAPPC9,NIBP antibody) at dilution of 1:800

Immunohistochemical of paraffin-embedded human kidney using Catalog No:116346(TRAPPC9,NIBP antibody) at dilution of 1:50 (under 10x lens)
Immunohistochemical of paraffin-embedded human kidney using Catalog No:116346(TRAPPC9,NIBP antibody) at dilution of 1:50 (under 40x lens)

IP Result of anti-TRAPPC9,NIBP (IP:Catalog No:116346, 4ug; Detection:Catalog No:116346 1:500) with mouse brain tissue lysate 3600ug.

Immunofluorescent analysis of HEK-293 cells using Catalog No:116346(TRAPPC9,NIBP Antibody) at dilution of 1:50 and Alexa Fluor 488-congugated AffiniPure Goat Anti-Rabbit IgG(H+L)
-
Background
TRAPPC9, also named as KIAA1882 and NIBP, belongs to the NIBP family. It functions as an activator of NF-kappa-B through increased phosphorylation of the IKK complex. TRAPPC9 may function in neuronal cells differentiation and play a role in vesicular transport from endoplasmic reticulum to Golgi. TRAPPC9 was found in neurons of the cerebral cortex, hippocampus, and deep gray matter. Western blotting indicates molecular weight of TRAPPC9 is 130-140 kDa, and 250 kDa may be detected with extensive posttranslational modification of TRAPPC9.
-
References
- Westlake CJ, Baye LM, Nachury MV. Primary cilia membrane assembly is initiated by Rab11 and transport protein particle II (TRAPPII) complex-dependent trafficking of Rabin8 to the centrosome. Proceedings of the National Academy of Sciences of the United States of America. 108(7):2759-64. 2011.
- Qin M, Liu S, Li A. NIK- and IKKβ-binding protein promotes colon cancer metastasis by activating the classical NF-κB pathway and MMPs. Tumour biology : the journal of the International Society for Oncodevelopmental Biology and Medicine. 2015.
Related Products / Services
Please note: All products are "FOR RESEARCH USE ONLY AND ARE NOT INTENDED FOR DIAGNOSTIC OR THERAPEUTIC USE"
